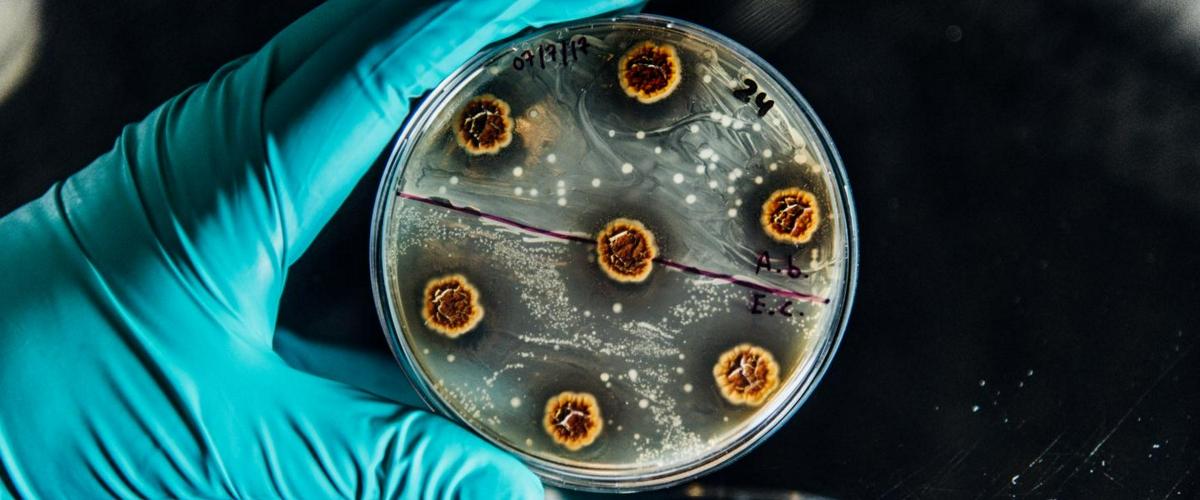
TODO:

В исследовании приняли участие 70 человек пожилого возраста, которые ежегодно после проведенной антибактериальной терапии сдавали анализы для идентификации в организме устойчивых бактерий Klebsiella pneumoniae и Escherichia coli. Ученые стремились понять, как долго они могут присутствовать в организме и к каким последствиям приводить.
Даже девять лет спустя в организме людей можно было обнаружить присутствие бактерий. Сначала они довольно быстро адаптировались к условиям колонизированных органов, а затем претерпевали незначительные генетические изменения, показали длительные наблюдения.
«Эти пациенты не только многократно заболевают сами, но и выступают источником инфекции для других — резервуаром патогенов», — заявила соавтор работы Лисандра Агилар Бултет.
Результаты имеют очень важное значение для совершенствования протоколов лечения и профилактики. Например, понимая длительность сохранения устойчивых бактерий в организме людей, можно заранее предполагать потенциальную неэффективность некоторых антибиотиков даже через несколько лет после их первоначального применения.
Ранее другая группа исследователей изучала механизм передачи инструкций между бактериями для формирования резистентности и определила способ для его блокировки.